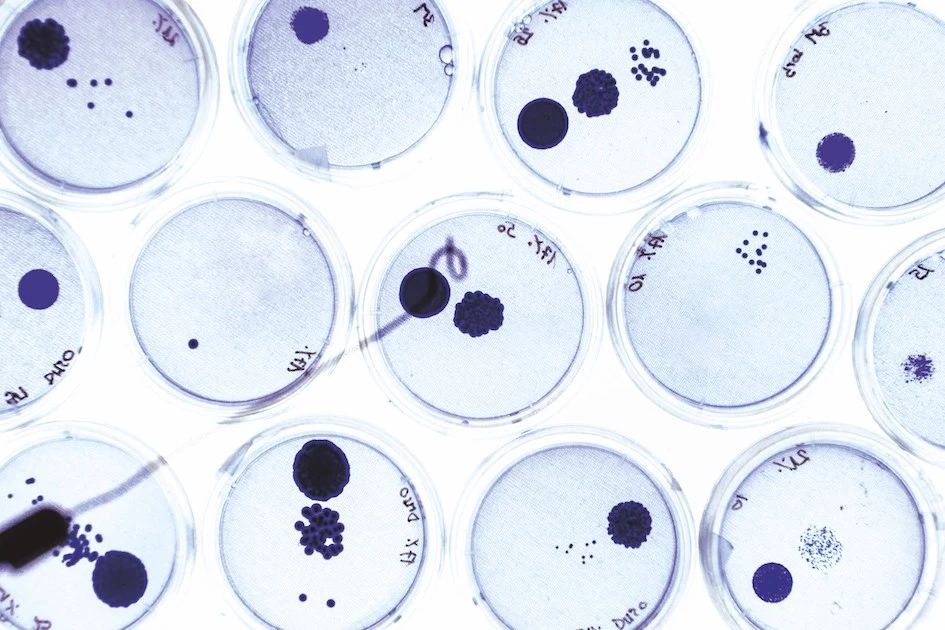

据 2018 年澳大利亚卓越研究 (ERA) 评估报告显示,弗林德斯大学 (Fliners University) 科研实力世界领先, 10 项 科研领域取得了五星评级获评为“ 远高于世界水平 ”,相较于 2015 年评估中的 5 项科研领域,科研成果翻了一番。这一结果 巩固了我们作为世界一流研究型大学的声誉 。
此外,弗林德斯大学 12项 科研领域取得了四星评级,获评为“ 高于世界水平 ”,还有 22 项 科研领域获得“ 达到世界水平 ”的三星评级。
弗林德斯大学校长 Colin Stirling 教授表示:“我们在这些科研领域表现的提升也部分归因于我们的战略任命,即在具有战略意义的领域增强实力与深度。近期宣布 额外投入 100 万澳元用于未来五年的科研建设 ,相信我们的表现会更加令人瞩目。

弗林德斯大学的科研工作者们致力于通过高质量的研究为世界带来积极影响,科研副校长 Robert Saint 教授对此表示了称赞。
衷心感谢全体研究人员的辛勤付出,特别是那些推动4位数编码特定研究领域排名以及正在为实现科研领域排名相当于或高于世界其他地区而努力的科研人员。
值得一提的是,我们优异结果中的新成员—— 药物与生物分子化学 首次 获得远高于世界水平的五星评级 。 2015 年,进化生物学曾获得‘达到世界水平’的三星评级, 2018 年,该学科一跃获得‘远高于世界水平’的五星评级。此外, 植物生物学、凝聚态物理学、肿瘤学和癌症发生、物理化学与材料工程均由四星上升至五星评级 。
在 2012 年和 2015 年的排名中,我们持续在 物理 、 化学 、 医学 的各项领域取得傲人成绩,巩固了这些领域的五星评级,尤其是 纳米技术 、 心血管医学 和 血液学 以及 眼科学与验光科学 。
这些结果反映出我们在创新和突破性研究领域的领先地位,这些研究已经超越了我们的校园范围,涉及商业、工业和社区。
远高于世界水平
- 心血管医学与血液学 Cariovascular Meicine an Haematology
- 凝聚态物理学 Conense Matter Physics
- 进化生物学 Evolutionary Biology
- 材料工程 Materials Engineering
- 药物和生物分子化学 Meicinal & Biomolecular Chemistry
- 纳米技术 Nanotechnology
- 肿瘤学与癌症发生 Oncology & Carcinogenesis
- 眼科学与验光科学 Ophthalmology an Optometry
- 物理化学 Physical Chemistry
- 植物生物学 Plant Biology
高于世界水平
临床科学 Clinical Sciences
犯罪学 Criminology
生态学 Ecology
护理学 Nursing
营养学和饮食学 Nutrition an Dietetics
儿科学与生殖医学 Paeiatrics an Reprouctive Meicine
药理学与药物科学 Pharmacology an Pharmaceutical Sciences
自然地理学与环境地球科学 Physical Geography an Environmental Geoscience
政策与管理学 Policy an Aministration
心理学 Psychology
表演艺术与创意写作 Performing Arts an Creative Writing
动物学 Zoology
达到 世界水平 ****
- 考古学 Archaeology
- 原子、分子、核、粒子和等离子体物理学 Atomic, Molecular, Nuclear, Particle an Plasma Physics
- 生物医学工程 Biomeical Engineering
- 土木工程 Civil Engineering
- 文化研究 Cultural Stuies
- 课程与教育法 Curriculum an Peagogy
- 电影、电视与数字媒体 Film, Television an Digital Meia
- 渔业(水产)科学 Fisheries Sciences
- 历史研究 Historical Stuies
- 人类地理学 Human Geography
- 人体运动与运动科学 Human Movement an Sports Science
- 工业生物技术 Inustrial Biotechnology
- 法学 Law
- 文学研究 Literary Stuies
- 神经科学 Neurosciences
- 哲学 Philosophy
- 自然地理学与环境地球科学 Physical Geography an Environmental Geoscience
- 政治学 Political Science
- 公众健康与健康服务 Public Health an Health Services
- 社会工作 Social Work
- 社会学 Sociology
- 教育中的特殊研究 Specialist Stuies in Eucation
关于 ERA 2018 年澳大利亚卓越研究报告 (ERA) 由澳大利亚研究理事会 (ARC) 领导,经由国际认可的专家通过使用指标与评审相结合的方式对澳大利亚高等教育机构的研究成果进行的评估结果。 ERA报告提供一个广泛的概览被称为 2 位数编码分析和一个更为全面的 4 位数编码评估。通过对 4 位数编码的关注,弗林德斯大学可以详细了解具体领域的结果。基于 4 位数编码结果, 弗林德斯大学约 90% 的科研达到或高于世界水平 。